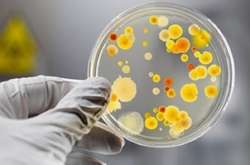
Львів’янин помер від лептоспірозу після невдалого самолікування

У Львові кардіохірурги вперше провели унікальну операцію на серці

Жінці замінили мітральний клапан, не розрізаючи грудину
Кардіохірурги Львівської обласної клінічної лікарні 2 листопада вперше в Західній Україні провели унікальну операцію -замінили 55-річній жінці з Івано-Франківщини Марії Борисюк мітральний клапан, не розрізаючи грудину. До серця вони дісталися через невеликий розріз (8 см) між ребрами.У майбутньому таких мініінвазивних операцій буде більше, а розрізи ще менші – 4-3 см. Про це повідомляє Захід.net.
На четвертий день після операції жінка була вже у звичайній палаті, в реанімації провела лише день. Її, як повідомили лікарі, за станом здоров'я можна вже виписувати додому, та оскільки це перша пацієнтка, якій зробили таку мініінвазивну операцію, то за нею поспостерігають ще днів два і тоді випишуть.
У жінки діагностували ревматизм серця. Значній частині людей з таким захворюванням, рано чи пізно, як розповів керівник клініки хірургії серця Львівського національного медуніверситету ім. Д. Галицького, професор Любомир Кулик, треба міняти мітральний клапан. І Марія Борисюк потрапила в цей список.

Після ретельних обстежень кардіохірурги дійшли висновку: пацієнтці потрібна операція із заміни мітрального клапана. І що швидше цю операцію провести, то кращим буде стан пацієнтки.
Операції із заміни мітрального клапана, як і пластику клапана (остання операція набагато складніша) в кардіохірургічному відділенні обласної лікарні проводять давно. І таких операцій роблять до 100 щороку. Але досі проводили їх класичним способом: аби добратися до серця, пацієнту розрізали грудину сантиметрів на 20. Це доволі великий розріз і кардіохірургу було зручно і комфортно працювати.
Та для пацієнта це була доволі травматична операція. Кардіохірурги робили медичний перелом грудини, який заживав приблизно 1,5 місяця. Після операції пацієнту було важко дихати, боляче відкашлювати. На місці розтину інколи утворювалися потовщені рубці, що морально травмувало хворих, особливо жінок, адже з такими шрамами засмагати в купальнику не будеш. Білизна могла травмувати рубець і це створювало дискомфорт. Інколи грудина погано зросталася, виникало її запалення, що було дуже небезпечно для пацієнта.
І 2 листопада операційна бригада, до якої увійшли кардіохірурги Любомир Кулик, Дмитро Бешлей, Ігор Процик, Станіслав Ліщенко, перфузіолог Тарас Фіалка і анестезіолог Мар'яна Лисько вирішили провести першу мініінвазивну операцію з заміни мітрального клапана у Львові. Їхньою пацієнткою стала Марія Борисюк.
До серця пані Марії кардіохірурги добралися через розріз (8 см) між ребрами. Їх не чіпали, лише трохи розсунули. Через отвір, що утворився, спеціальними інструментами (їх подарували колеги зі США) видалили зношений мітральний клапан і поставили новий механічний, який прослужить пацієнтці не один десяток років.

Коментарі — 0